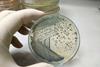
shutterstock_2245939183

All Technology articles – Page 10
-
 Article
ArticleQuality from the start: designing a scalable AAV production platform
This Feature Partnership discusses AAVs and how manufacturers can overcome the key development challenges and create a scalable AAV production platform.
-
 News
NewsEuropean manufacturing facility to strengthen gene therapy supply
The new manufacturing facility in Finland will aid global supply of the first FDA-approved intravesical non-replicating gene therapy for adults with a common cancer.
-
 Article
ArticleHow ready are you? Preparing for the impact of EU GMP Annex 1 on primary packaging
This feature partnership covers how pharma companies can ensure they are end-to-end compliant with Annex 1 for their primary packaging via a robust CCS.
-
 Article
ArticleEnvironmental Monitoring In-Depth Focus 2024
This in-depth focus explores environmental monitoring of compressed gas ports and best practice for minimising contamination risks.
-
 Article
ArticleEuropean Pharmaceutical Review Issue 4 2024
European Pharmaceutical Review Issue 4 includes articles on regulation, bioproduction, environmental monitoring, packaging and drug delivery.
-
 News
NewsOptimising wet granulation manufacturing with advanced technologies
The approach proposed in the paper suggests how artificial intelligence (AI) and machine learning (ML) could enhance process efficiency and product quality during complex manufacturing.
-
 News
NewsRadiopharmaceutical therapy delivers promising meningioma survival rates
The Phase II clinical trial is the first completed prospective trial for refractory meningiomas with a tumour growth rate of 15 percent or more over six months.
-
 News
NewsPharmaLab Congress 2024 - what’s new for the third year in Düsseldorf/Neuss
Find out what is on offer for pharma professionals working in analytical development and microbiology QC at the 12th PharmaLab Congress being held in Germany in 2024.
-
 News
NewsMicrobial contamination detection with rapid spectroscopy
The detection method was designed for continuous culture monitoring of cell therapy products and required minimal sample preparation, research showed.
-
 Report
ReportPharma Horizons: Biologics
European Pharmaceutical Review’s latest Pharma Horizons report provides insight on key developments in pharmaceutical biologics for drug development, pharmaceutical manufacturing and quality control.
-
 News
NewsSepsis: addressing unmet needs for a global priority
Limited funding and a lack of drugs targeting the root cause of sepsis are some of the current obstacles when addressing the disease burden, GlobalData says.
-
 News
NewsLilly $1.8 billion investment to bolster Irish manufacturing
The expansion is planned to support production of Eli Lilly and Company’s medicines for diabetes, obesity and Alzheimer's and both sites will harness advanced technology and sustainability capabilities.
-
 News
NewsInnovative medicine production site inaugurated in France
Sanofi’s novel manufacturing unit in France shortens production timelines and enables rapid changes in production capacities for medicines such as biologics and vaccines.
-
 News
NewsGene therapy trial facilitates major vision improvement
Some of the rare disease participants experienced fast and sustained improvement in their eyesight during the clinical trial, data shows.
-
 News
NewsImproving upstream fermentation with end-to-end automation
The automated system “significantly improved process control”, resulting in greater productivity of a small-molecule drug substance.
-
 News
NewsSustainable PFAS-free synthesis for pharmaceutical compounds
The novel, environmentally-friendly synthesis strategy holds potential for manufacturing scale up, according to the research.
-
 News
NewsNovartis collaboration to innovate subcutaneous drug delivery
The multi-target biologic-focused agreement could enhance treatment convenience by improving subcutaneous administration options for patients.
-
News
AstraZeneca investment to increase biologic capacity in Sweden
The planned expansion is set to strengthen AstraZeneca’s capability to manufacture biologic medicines for patients globally.
-
News
NewsSemi-automatic method could provide “superior” bacterial characterisation analysis
The analysis technique offers “significant” advantages over traditional colony forming unit (CFU) counts, according to the paper.
-
 News
NewsInnovative mass spec method may improve oligonucleotide therapeutic analysis
The nonIP-RP-LC-MS method provides an “easy, reliable, and cost-effective” approach for bioanalysing oligonucleotide therapies.



